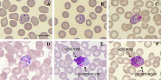

Morphological atypia and molecular profile of Plasmodium vivax: Findings from an outbreak in the Brazilian Amazon
- PMID: 37772844
- PMCID: PMC10540677
- DOI: 10.1051/parasite/2023039
Morphological atypia and molecular profile of Plasmodium vivax: Findings from an outbreak in the Brazilian Amazon
Abstract
This study aimed to perform morphological and molecular analyses of parasites isolated from the blood of malaria-infected individuals during an outbreak in the Microregion of Cametá, State of Pará, Brazilian Amazon. A total of 260 positive samples were identified by microscopy as Plasmodium vivax; however, in three samples, forms considered unusual for the species were found and defined as morphological atypia of P. vivax. Single P. vivax infection was confirmed by qPCR in all samples. Among 256 genotyped samples, the VK247 genotype alone was identified in 255 samples, and the VK210 genotype was found in only one. The study showed that this malaria outbreak was caused by the etiological agent P. vivax, and for the first time, morphological atypia was described in isolates circulating in Brazil. Likewise, for the first time, the VK247 genotype was detected predominantly in single infections in an area of the State of Pará, which may suggest a greater circulation of the genotype in the region.
Title: Atypie morphologique et profil moléculaire de Plasmodium vivax : résultats issus d’une épidémie en Amazonie brésilienne.
Abstract: Cette étude visait à effectuer des analyses morphologiques et moléculaires de parasites isolés du sang d’individus infectés par le paludisme lors d’une épidémie dans la microrégion de Cametá, État du Pará, Amazonie brésilienne. Au total, 260 échantillons positifs ont été identifiés par microscopie comme Plasmodium vivax mais dans trois échantillons, des formes considérées comme inhabituelles pour l’espèce ont été trouvées et définies comme des atypies morphologiques de P. vivax. Une infection simple à P. vivax a été confirmée par qPCR dans tous les échantillons. Sur 256 échantillons génotypés, le génotype VK247 seul a été identifié dans 255 échantillons, et le génotype VK210 a été trouvé dans un seul échantillon. L’étude a montré que cette épidémie de paludisme était causée par l’agent étiologique P. vivax et, pour la première fois, une atypie morphologique a été décrite dans des isolats circulant au Brésil. De même, pour la première fois, le génotype VK247 a été détecté principalement dans des infections uniques dans une zone de l’État de Pará, ce qui peut suggérer une plus grande circulation du génotype dans la région.
Keywords: Genotyping; Morphological atypia; Outbreak; Plasmodium vivax.
© ACJ Alves et al., published by EDP Sciences, 2023.
Conflict of interest statement
The authors declare that they have no competing interests.
Figures

References
-
- Arnot DE, Barnwell JW, Tam JP, Nussenzweig V, Nussenzweig RS, Enea V. 1985. Circumsporozoite protein of Plasmodium vivax: gene cloning and characterization of the immunodominant epitope. Science, 230, 815–818. - PubMed
-
- Brazil. 2023. Epidemiological summary – Malaria. http://200.214.130.44/sivep_malaria/ (accessed 2.23.23).
-
- Brazil. 2009. Manual of Laboratory Diagnosis of Malaria. Secretariat of Health Surveillance, Ministry of Health of Brazil: Brasília.
-
- Brazil. 2020. Guide for the treatment of malaria in Brazil. Secretariat of Health Surveillance, Ministry of Health of Brazil: Brasília.
MeSH terms
Substances
Grants and funding
LinkOut - more resources
Full Text Sources
Medical
